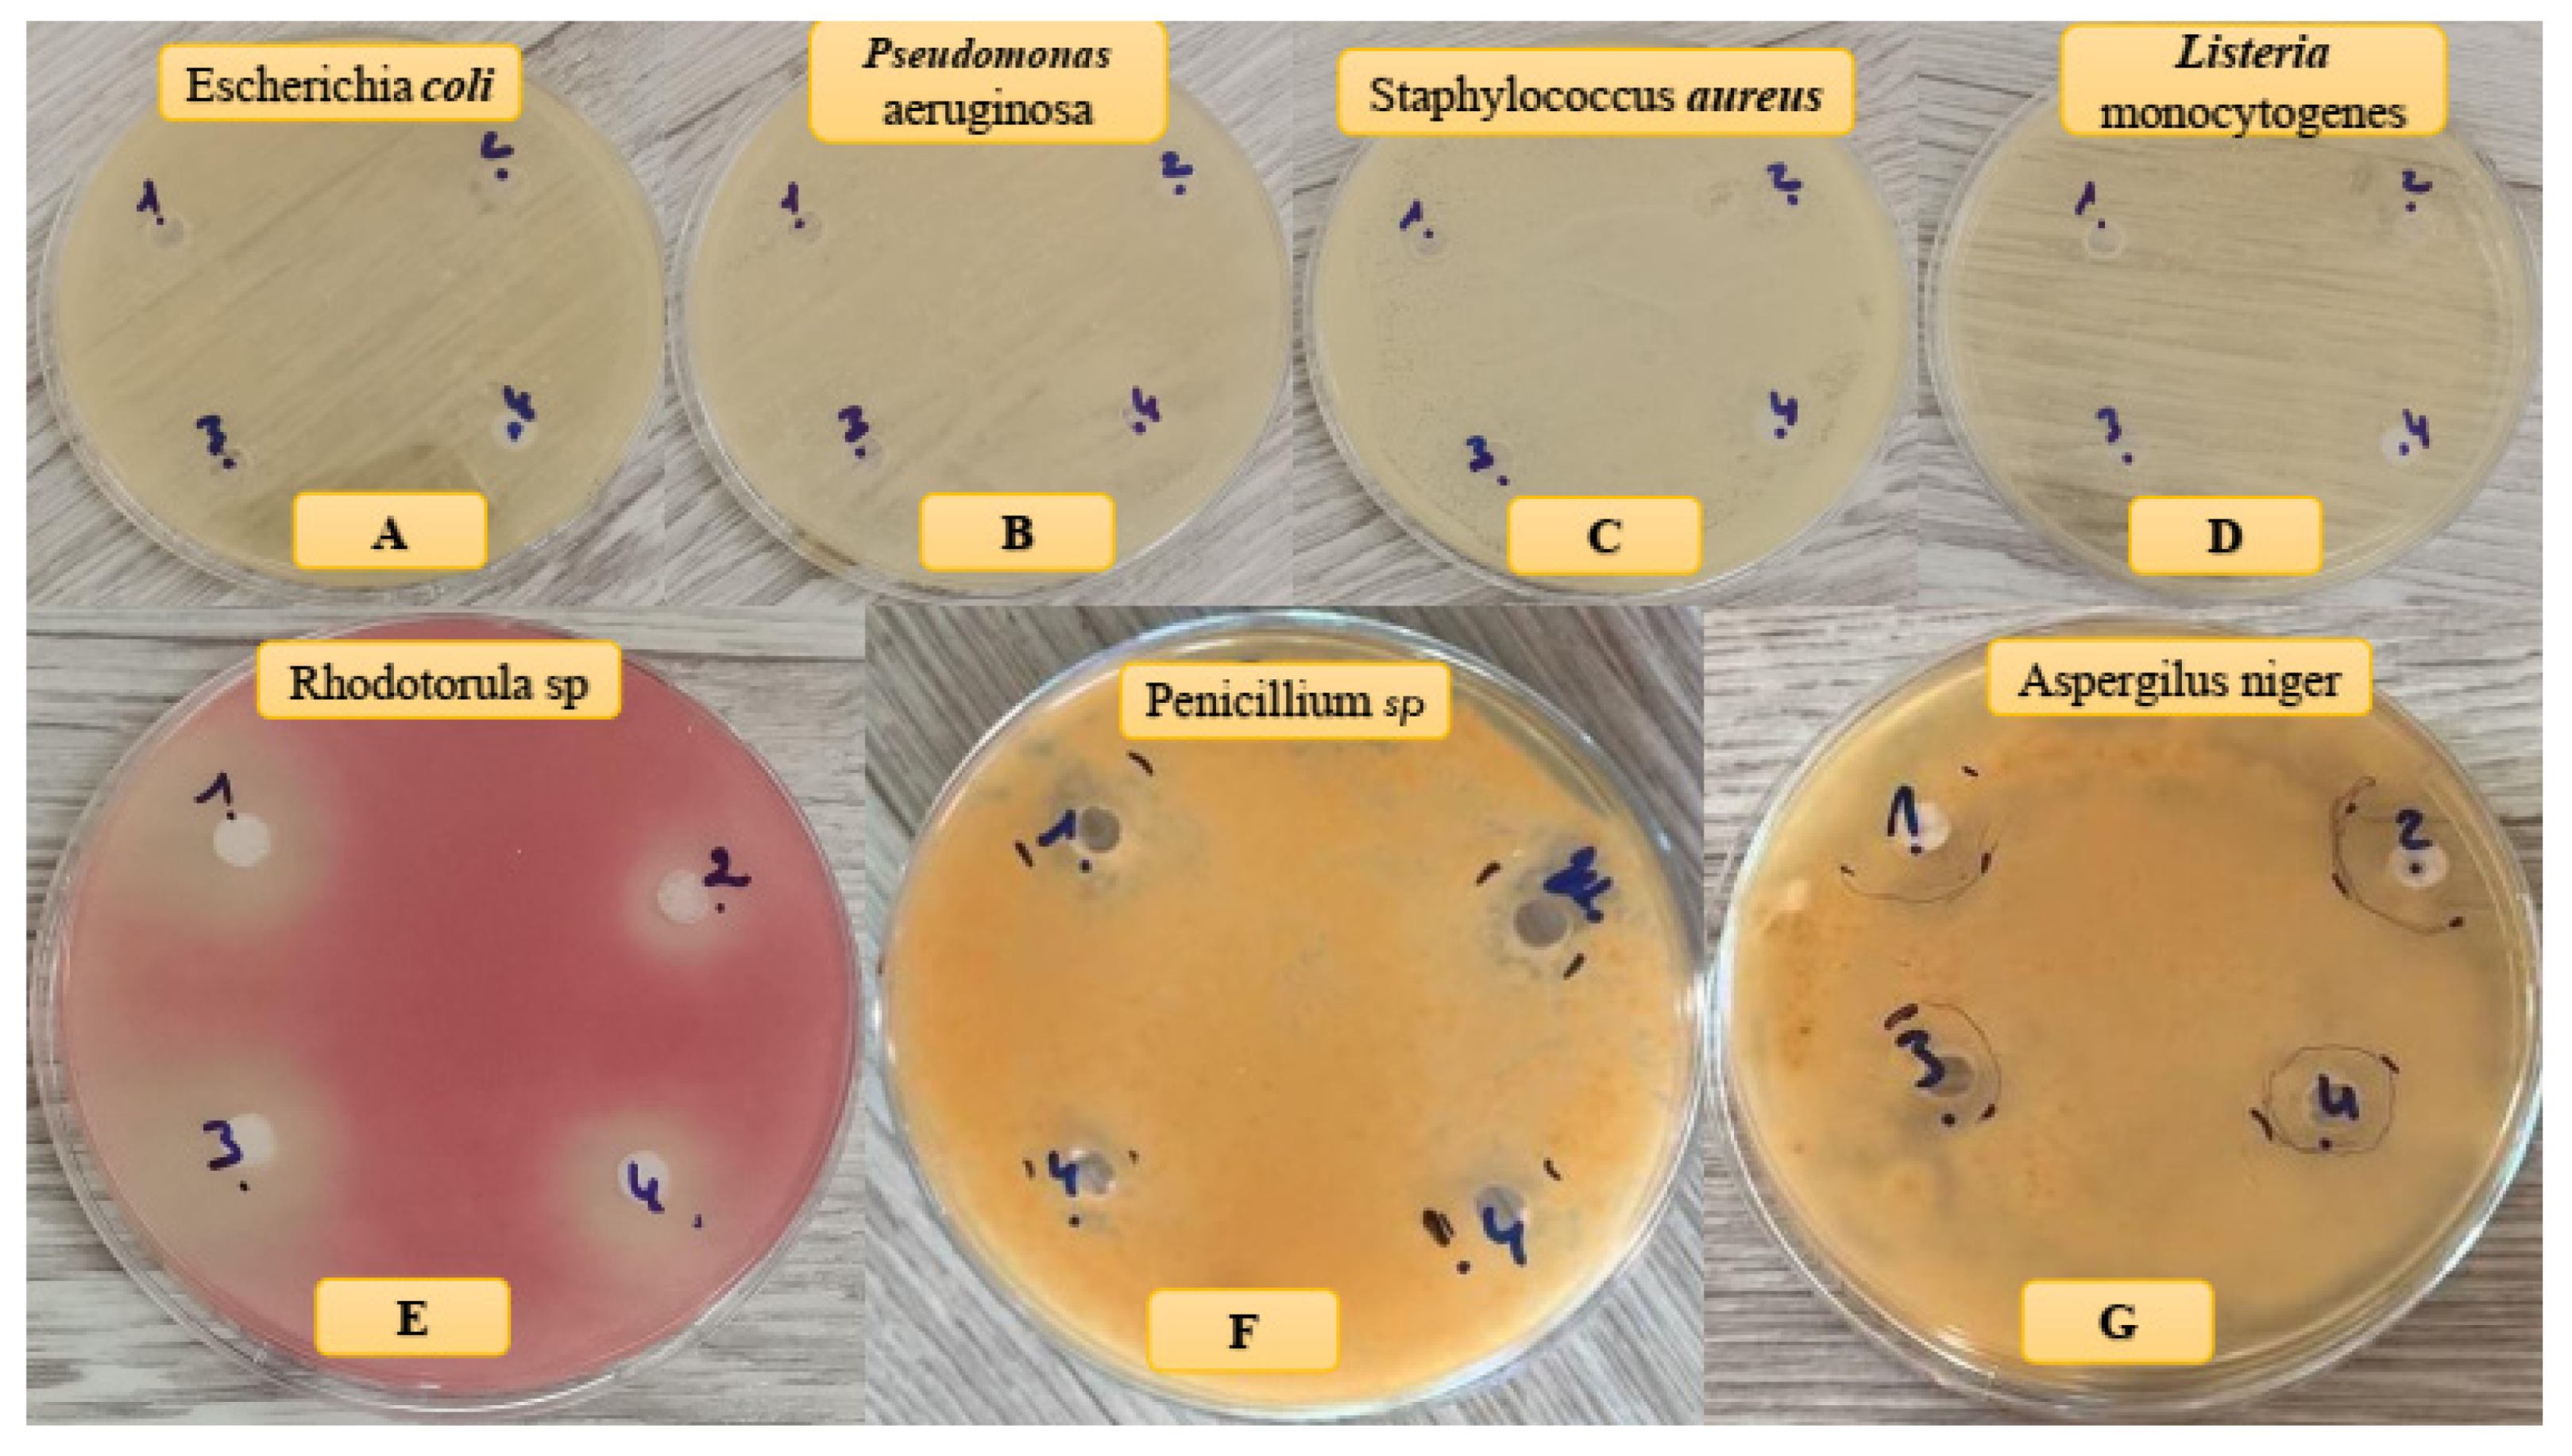
Polymers 16 00085 g008 Polymers 16 00085 g008

Cheminformatics-Based Design and Synthesis of Hydroxyapatite/Collagen Nanocomposites for Biomedical Applications
Abstract
1. Introduction
2. Materials and Methods
2.1. Materials
2.2. Attenuated Total Reflectance–Fourier Transform Infrared Spectroscopy (ATR-FTIR)
2.3. X-ray Diffraction Analysis with Energy-Dispersive X-ray Spectroscopy (XRD-EDX)
2.4. Thermogravimetric Analysis (TGA)
2.5. Scanning Electron Microscopy (SEM) with Energy-Dispersive X-ray Spectroscopy (EDX)
2.6. Molecular Docking and Structure Preparation for HAp–Collagen Complexes
2.7. In Silico ADME Screening
2.8. Composite Synthesis the Dissolution/Precipitation Method
2.8.1. HAp Synthesis
2.8.2. Composite Synthesis
2.9. Study of the Antimicrobial Activity
2.9.1. Antibacterial Activity
2.9.2. Antifungal Activity
3. Results and Discussion
3.1. Chemical Composition of Composites
3.2. X-ray Diffraction Analysis of Composites
3.3. Thermal Stability of Composites
3.4. SEM-Based Morphological Study
3.5. Microbial Activity
3.6. Molecular Modeling
3.7. In Silico ADME Predictions
4. Conclusions
Author Contributions
Funding
Institutional Review Board Statement
Data Availability Statement
Acknowledgments
Conflicts of Interest
References
- Kirmanidou, Y.; Sidira, M.; Drosou, M.-E.; Bennani, V.; Bakopoulou, A.; Tsouknidas, A.; Michailidis, N.; Michalakis, K. New Ti-alloys and surface modifications to improve the mechanical properties and the biological response to orthopedic and dental implants: A review. BioMed Res. Int. 2016, 2016, 2908570. [Google Scholar] [CrossRef] [PubMed]
- Memarzadeh, K.; Sharili, A.S.; Huang, J.; Rawlinson, S.C.; Allaker, R.P. Nanoparticulate zinc oxide as a coating material for orthopedic and dental implants. J. Biomed. Mater. Res. Part A 2015, 103, 981–989. [Google Scholar] [CrossRef] [PubMed]
- Lowenstam, H.A.; Weiner, S. On Biomineralization; Oxford University Press on Demand: Oxford, UK, 1989. [Google Scholar]
- Akartasse, N.; Azzaoui, K.; Mejdoubi, E.; Hammouti, B.; Elansari, L.L.; Abou-Salama, M.; Aaddouz, M.; Sabbahi, R.; Rhazi, L.; Siaj, M. Environmental-friendly adsorbent composite based on hydroxyapatite/hydroxypropyl methyl-cellulose for removal of cationic dyes from an aqueous solution. Polymers 2022, 14, 2147. [Google Scholar] [CrossRef] [PubMed]
- Yang, D.; Xiao, J.; Wang, B.; Li, L.; Kong, X.; Liao, J. The immune reaction and degradation fate of scaffold in cartilage/bone tissue engineering. Mater. Sci. Eng. C 2019, 104, 109927. [Google Scholar] [CrossRef] [PubMed]
- Azzaoui, K.; Lamhamdi, A.; Mejdoubi, E.M.; Berrabah, M.; Hammouti, B.; Elidrissi, A.; Fouda, M.M.; Al-Deyab, S.S. Synthesis and characterization of composite based on cellulose acetate and hydroxyapatite application to the absorption of harmful substances. Carbohydr. Polym. 2014, 111, 41–46. [Google Scholar] [CrossRef] [PubMed]
- Ansari, E.G. Etudes de la Conception et Des Différentes Propriétés d’un Nouveau Revêtement Bioactif de Stents Endovasculaires à Base de Poly (Acide [R, S]-3, 3-Diméthylmalique)(PDMMLA). Ph.D. Thesis, Université Paris-Nord-Paris XIII, Villetaneuse, France, 2021. [Google Scholar]
- Lakrat, M.; Fadlaoui, S.; Aaddouz, M.; El Asri, O.; Melhaoui, M.; El Miloud, M. Synthesis and characterization of composites based on hydroxyapatite nanoparticles and chitosan extracted from shells of the freshwater crab Potamon algeriense. Prog. Chem. Appl. Chitin Its Deriv. 2020, 25, 132–142. [Google Scholar] [CrossRef]
- Madni, A.; Kousar, R.; Naeem, N.; Wahid, F. Recent advancements in applications of chitosan-based biomaterials for skin tissue engineering. J. Bioresour. 2021, 6, 11–25. [Google Scholar] [CrossRef]
- Liu, X.; Ma, L.; Mao, Z.; Gao, C. Chitosan-based biomaterials for tissue repair and regeneration. In Chitosan for Biomaterials II; Springer: Berlin/Heidelberg, Germany, 2011; pp. 81–127. [Google Scholar]
- Aaddouz, M.; Azzaoui, K.; Akartasse, N.; Mejdoubi, E.; Hammouti, B.; Taleb, M.; Sabbahi, R.; Alshahateet, S.F. Removal of methylene blue from aqueous solution by adsorption onto hydroxyapatite nanoparticles. J. Mol. Struct. 2023, 1288, 135807. [Google Scholar] [CrossRef]
- Chen, F.; Zhu, Y.-J. Multifunctional calcium phosphate nanostructured materials and biomedical applications. Curr. Nanosci. 2014, 10, 465–485. [Google Scholar] [CrossRef]
- Suchanek, W.; Yoshimura, M. Processing and properties of hydroxyapatite-based biomaterials for use as hard tissue replacement implants. J. Mater. Res. 1998, 13, 94–117. [Google Scholar] [CrossRef]
- Zhou, Y.; Yao, H.; Wang, J.; Wang, D.; Liu, Q.; Li, Z. Greener synthesis of electrospun collagen/hydroxyapatite composite fibers with an excellent microstructure for bone tissue engineering. Int. J. Nanomed. 2015, 10, 3203. [Google Scholar]
- Sun, R.-X.; Lv, Y.; Niu, Y.-R.; Zhao, X.-H.; Cao, D.-S.; Tang, J.; Sun, X.-C.; Chen, K.-Z. Physicochemical and biological properties of bovine-derived porous hydroxyapatite/collagen composite and its hydroxyapatite powders. Ceram. Int. 2017, 43, 16792–16798. [Google Scholar] [CrossRef]
- Bernache-Assollant, D.; Ababou, A.; Champion, E.; Heughebaert, M. Sintering of calcium phosphate hydroxyapatite Ca10(PO4)6 (OH)2 I. Calcination and particle growth. J. Eur. Ceram. Soc. 2003, 23, 229–241. [Google Scholar] [CrossRef]
- Wagh, A. Chemically Bonded Phosphate Ceramics: Twenty-First Century Materials with Diverse Applications; Elsevier: Amsterdam, The Netherlands, 2016. [Google Scholar]
- Azzaoui, K.; Aaddouz, M.; Akartasse, N.; Mejdoubi, E.; Jodeh, S.; Hammouti, B.; Taleb, M.; ES-Sehli, S.; Berisha, A.; Rhazi, L.; et al. Synthesis of β-Tricalcium Phosphate/PEG 6000 Composite by Novel Dissolution/Precipitation Method: Optimization of the Adsorption Process Using a Factorial Design—DFT and Molecular Dynamic. Arab. J. Sci. Eng. 2023, 48, 1–22. [Google Scholar] [CrossRef]
- Avila Rodríguez, M.I.; Rodríguez Barroso, L.G.; Sánchez, M.L. Collagen: A review on its sources and potential cosmetic applications. J. Cosmet. Dermatol. 2018, 17, 20–26. [Google Scholar] [CrossRef] [PubMed]
- Buckley, M. Species identification of bovine, ovine and porcine type 1 collagen; comparing peptide mass fingerprinting and LC-based proteomics methods. Int. J. Mol. Sci. 2016, 17, 445. [Google Scholar] [CrossRef] [PubMed]
- Henriksen, K.; Karsdal, M. Type I collagen. In Biochemistry of Collagens, Laminins and Elastin; Elsevier: Amsterdam, The Netherlands, 2016; pp. 1–11. [Google Scholar]
- Mallick, M.; Are, R.P.; Babu, A.R. An overview of collagen/bioceramic and synthetic collagen for bone tissue engineering. Materialia 2022, 22, 101391. [Google Scholar] [CrossRef]
- Mushtaq, A.; Zhao, R.; Luo, D.; Dempsey, E.; Wang, X.; Iqbal, M.Z.; Kong, X. Magnetic hydroxyapatite nanocomposites: The advances from synthesis to biomedical applications. Mater. Des. 2021, 197, 109269. [Google Scholar] [CrossRef]
- Mudhafar, M.; Zainol, I.; Alsailawi, H.; Aiza Jaafar, C. Synthesis and characterization of fish scales of hydroxyapatite/collagen–silver nanoparticles composites for the applications of bone filler. J. Korean Ceram. Soc. 2021, 59, 229–239. [Google Scholar] [CrossRef]
- Halim, N.A.A.; Hussein, M.Z.; Kandar, M.K. Nanomaterials-upconverted hydroxyapatite for bone tissue engineering and a platform for drug delivery. Int. J. Nanomed. 2021, 16, 6477. [Google Scholar] [CrossRef]
- Pelin, I.M.; Maier, S.S.; Chitanu, G.C.; Bulacovschi, V. Preparation and characterization of a hydroxyapatite–collagen composite as component for injectable bone substitute. Mater. Sci. Eng. C 2009, 29, 2188–2194. [Google Scholar] [CrossRef]
- Stoch, A.; Jastrze, W.; Długoń, E.; Lejda, W.; Trybalska, B.; Stoch, G.; Adamczyk, A. Sol–gel derived hydroxyapatite coatings on titanium and its alloy Ti6Al4V. J. Mol. Struct. 2005, 744, 633–640. [Google Scholar] [CrossRef]
- Teng, S.-H.; Lee, E.-J.; Wang, P.; Kim, H.-E. Collagen/hydroxyapatite composite nanofibers by electrospinning. Mater. Lett. 2008, 62, 3055–3058. [Google Scholar] [CrossRef]
- Ficai, A.; Andronescu, E.; Trandafir, V.; Ghitulica, C.; Voicu, G. Collagen/hydroxyapatite composite obtained by electric field orientation. Mater. Lett. 2010, 64, 541–544. [Google Scholar] [CrossRef]
- Chang, M.C.; Tanaka, J. FT-IR study for hydroxyapatite/collagen nanocomposite cross-linked by glutaraldehyde. Biomaterials 2002, 23, 4811–4818. [Google Scholar] [CrossRef] [PubMed]
- Shityakov, S.; Förster, C. In silico predictive model to determine vector-mediated transport properties for the blood–brain barrier choline transporter. Adv. Appl. Bioinform. Chem. 2014, 7, 23–36. [Google Scholar] [CrossRef] [PubMed]
- Shityakov, S.; Skorb, E.V.; Förster, C.Y.; Dandekar, T. Scaffold Searching of FDA and EMA-Approved Drugs Identifies Lead Candidates for Drug Repurposing in Alzheimer’s Disease. Front. Chem. 2021, 9, 736509. [Google Scholar] [CrossRef]
- Daina, A.; Michielin, O.; Zoete, V. SwissADME: A free web tool to evaluate pharmacokinetics, drug-likeness and medicinal chemistry friendliness of small molecules. Sci. Rep. 2017, 7, 42717. [Google Scholar] [CrossRef]
- van Velthoven, M.H.; Cordon, C.; Challagalla, G. Digitization of healthcare organizations: The digital health landscape and information theory. Int. J. Med. Inform. 2019, 124, 49–57. [Google Scholar] [CrossRef]
- Ranjith, D.; Ravikumar, C. SwissADME predictions of pharmacokinetics and drug-likeness properties of small molecules present in Ipomoea mauritiana Jacq. J. Pharmacogn. Phytochem. 2019, 8, 2063–2073. [Google Scholar]
- Youssoufi, M.H.; Sahu, P.K.; Sahu, P.K.; Agarwal, D.D.; Ahmad, M.; Messali, M.; Lahsasni, S.; Ben Hadda, T. POM analyses of antimicrobial activity of 4 H-pyrimido [2, 1-b] benzothiazole, pyrazole, and benzylidene derivatives of curcumin. Med. Chem. Res. 2015, 24, 2381–2392. [Google Scholar] [CrossRef]
- Chohan, Z.H.; Sumrra, S.H.; Youssoufi, M.H.; Hadda, T.B. Design and synthesis of triazole Schiff bases and their oxovanadium (IV) complexes as antimicrobial agents. J. Coord. Chem. 2010, 63, 3981–3998. [Google Scholar] [CrossRef]
- Sheikh, J.; Parvez, A.; Juneja, H.; Ingle, V.; Chohan, Z.; Youssoufi, M.; Hadda, T.B. Synthesis, biopharmaceutical characterization, antimicrobial and antioxidant activities of 1-(4′-O-β-d-glucopyranosyloxy-2′-hydroxyphenyl)-3-aryl-propane-1, 3-diones. Eur. J. Med. Chem. 2011, 46, 1390–1399. [Google Scholar] [CrossRef]
- Agougui, H.; Sebeia, N.; Jabli, M.; El-Ghoul, Y. Synthesis of hydroxyapatite-sodium metasilicate via double decomposition method: Characterization and application to the removal of methylene blue. Inorg. Chem. Commun. 2021, 133, 108986. [Google Scholar] [CrossRef]
- Celiktas, O.Y.; Kocabas, E.H.; Bedir, E.; Sukan, F.V.; Ozek, T.; Baser, K. Antimicrobial activities of methanol extracts and essential oils of Rosmarinus officinalis, depending on location and seasonal variations. Food Chem. 2007, 100, 553–559. [Google Scholar] [CrossRef]
- Pundir, C.S.; Rawal, R. Determination of sulfite with emphasis on biosensing methods: A review. Anal. Bioanal. Chem. 2013, 405, 3049–3062. [Google Scholar] [CrossRef] [PubMed]
- Pundir, R.K.; Kashyap, S.R.N.; Kaur, A. Probiotic potential of lactic acid bacteria isolated from food samples: An in vitro study. J. Appl. Pharm. Sci. 2013, 3, 85–93. [Google Scholar]
- Maxian, S.H.; Zawadsky, J.P.; Dunn, M.G. In vitro evaluation of amorphous calcium phosphate and poorly crystallized hydroxyapatite coatings on titanium implants. J. Biomed. Mater. Res. 1993, 27, 111–117. [Google Scholar] [CrossRef]
- Almora-Barrios, N.; De Leeuw, N.H. Molecular dynamics simulation of the early stages of nucleation of hydroxyapatite at a collagen template. Cryst. Growth Des. 2012, 12, 756–763. [Google Scholar] [CrossRef]
- Bhowmik, A.; Khan, L.A.; Akhter, M.; Rokeya, B. Studies on the antidiabetic effects of Mangifera indica stem-barks and leaves on nondiabetic, type 1 and 2 diabetic model rats. Bangladesh J. Pharmacol. 2009, 4, 110–114. [Google Scholar] [CrossRef][Green Version]
- Libonati, F.; Nair, A.K.; Vergani, L.; Buehler, M.J. Mechanics of collagen–hydroxyapatite model nanocomposites. Mech. Res. Commun. 2014, 58, 17–23. [Google Scholar] [CrossRef]

| Collagen Type I (%) | Hydroxyapatite (%) | |
|---|---|---|
| Col 0 | 0 | 100 |
| Col 1 | 5 | 95 |
| Col 2 | 10 | 90 |
| Col 3 | 30 | 70 |
| Col 4 | 100 | 0 |
| Compound | Plane (hkl) | Dmean (nm) |
|---|---|---|
| Col 0 | (0 0 2) | 22.62 ± 2.10 |
| (3 1 0) | ||
| Col 2 | (0 0 2) | 21.49 ± 2.30 |
| (3 1 0) | ||
| Col 3 | (0 0 2) | 17.37 ± 3.00 |
| (3 1 0) | ||
| Col 4 | (0 0 2) | 14.81 ± 2.50 |
| (3 1 0) | ||
| (3 1 0) |
| Residue (%) | Degradation (%) | |
|---|---|---|
| Col 0 | 92.0717 | 7.9283 |
| Col 1 | 90.9019 | 9.0981 |
| Col 2 | 82.1458 | 17.8542 |
| Col 3 | 79.3054 | 20.6946 |
| Col 4 | 0.0889 | 99.9111 |
| Col 0 | Col 1 | Col 2 | Col 3 | Cycloheximide | DMSO | |
|---|---|---|---|---|---|---|
| Penicillium digitatum | 17.1 ± 0.4 | 13.5 ± 0.2 | 11.5 ± 0.2 | 14.3 ± 0.2 | 29.1 ± 0.3 | 00 ± 00 |
| Aspergilus niger | 12.1 ± 0.1 | 15.1 ± 0.2 | 18.03 ± 0.3 | 19.2 ± 0.1 | 22.3 ± 0.02 | 00 ± 00 |
| Rhodotorula glutinis | 13 ± 0.3 | 11.3 ± 0.1 | 10.5 ± 0.2 | 11 ± 0.1 | 28.1 ± 0.1 | 00 ± 00 |
| Escherichia coli | 7.8 ± 0.1 | 8.1 ± 0.3 | 00 ± 00 | 00 ± 00 | 31 ± 0.1 | 00 ± 00 |
| Pseudomonas aeruginosa | 00 ± 00 | 7.2 ± 0.1 | 00 ± 00 | 00 ± 00 | 21 ± 0.2 | 00 ± 00 |
| Staphylococcus aureus | 8 ± 0.2 | 00 ± 00 | 00 ± 00 | 00 ± 00 | 30.7 ± 0.3 | 00 ± 00 |
| Listeria monocytogenes | 00 ± 00 | 00 ± 00 | 00 ± 00 | 00 ± 00 | 30.3 ± 0.2 | 00 ± 00 |
| Complex | Binding Energy (Kcal/mol) | Ki (µM) | MItot (%) | |
|---|---|---|---|---|
| Col 1 | −45.96 | −8.2 | 0.98 | 43.01 |
| Col 2 | −32.74 | −7.9 | 1.63 | 31.62 |
| Col 3 | −15.69 | −5.7 | 66.68 | 34.95 |
| Pose | SASAavg | SASAsum | Rg |
|---|---|---|---|
| Ref | 1.03 | 367.01 | 21.92 |
| Col 1 | 0.82 | 288.85 | 10.86 |
| Col 2 | 0.76 | 267.77 | 10.97 |
| Col 3 | 0.62 | 218.41 | 8.41 |
| Physicochemical Properties | Lipophilicity | Water Solubility | ||||
|---|---|---|---|---|---|---|
| Formula | C57H91N19O16 | Log Po/w (iLOGP) | 2.94 | Log S (ESOL) | −1.08 | |
| Molecular weight | 1298.45 g/mol | Log Po/w (XLOGP3) | −5.13 | Solubility | 1.09 × 102 mg/mL; 8.38 × 10−2 mol/l | |
| No. of heavy atoms | 92 | Log Po/w (WLOGP) | −9.02 | Class | Very soluble | |
| No. of arom. heavy atoms | 6 | Log Po/w (MLOGP) | −7.04 | Log S (Ali) | −5.93 | |
| Fraction Csp3 | 0.61 | Log Po/w (SILICOS-IT) | 0.74 | Solubility | 1.53 × 10−3 mg/mL; 1.18 × 10−6 mol/l | |
| No. of rotatable bonds | 55 | Consensus Log Po/w | −3.50 | Class | Moderately soluble | |
| N H-bond acceptors | 22 | Log S (SILICOS-IT) | −8.20 | |||
| No. of H-bond donors | 18 | Solubility | 8.17 × 10−6 mg/mL; 6.30 × 10−9 mol/l | |||
| Molar Refractivity | 339.61 | Class | Poorly soluble | |||
| TPSA | 557.12 Å2 | |||||
| Pharmacokinetics | Drug-Likeness | Medicinal Chemistry | ||||
| GI absorption | Low | Lipinski | No; 3 violations: MW > 500, NorO > 10, NHorOH > 5 | PAINS | 0 alert | |
| BBB permeant | No | Ghose | No; 4 violations: MW > 480, WLOGP < −0.4, MR > 130, #atoms > 70 | Brenk | 4 alerts: beta_keto_anhydride, imine_1, imine_2, more_than_2_esters | |
| P-gp substrate | Yes | Veber | No; 2 violations: Rotors > 10, TPSA > 140 | Leadlikeness | No; 2 violations: MW > 350, Rotors > 7 | |
| CYP1A2 inhibitor | No | Egan | No; 1 violation: TPSA > 131.6 | Synthetic accessibility | 10.00 | |
| CYP2C19 inhibitor | No | Muegge | No; 6 violations: MW > 600, XLOGP3 < −2, TPSA > 150, Rotors > 15, H-acc > 10, H-don > 5 | |||
| CYP2C9 inhibitor | No | Bioavailability Score | 0.17 | |||
| CYP2D6 inhibitor | No | |||||
| CYP3A4 inhibitor | No | |||||
| Log Kp (skin permeation) | −17.86 cm/s | |||||
Disclaimer/Publisher’s Note: The statements, opinions and data contained in all publications are solely those of the individual author(s) and contributor(s) and not of MDPI and/or the editor(s). MDPI and/or the editor(s) disclaim responsibility for any injury to people or property resulting from any ideas, methods, instructions or products referred to in the content. |
© 2023 by the authors. Licensee MDPI, Basel, Switzerland. This article is an open access article distributed under the terms and conditions of the Creative Commons Attribution (CC BY) license (https://creativecommons.org/licenses/by/4.0/).
Share and Cite
Aaddouz, M.; Azzaoui, K.; Sabbahi, R.; Youssoufi, M.H.; Yahyaoui, M.I.; Asehraou, A.; El Miz, M.; Hammouti, B.; Shityakov, S.; Siaj, M.; et al. Cheminformatics-Based Design and Synthesis of Hydroxyapatite/Collagen Nanocomposites for Biomedical Applications. Polymers 2024, 16, 85. https://doi.org/10.3390/polym16010085
Aaddouz M, Azzaoui K, Sabbahi R, Youssoufi MH, Yahyaoui MI, Asehraou A, El Miz M, Hammouti B, Shityakov S, Siaj M, et al. Cheminformatics-Based Design and Synthesis of Hydroxyapatite/Collagen Nanocomposites for Biomedical Applications. Polymers. 2024; 16(1):85. https://doi.org/10.3390/polym16010085
Chicago/Turabian StyleAaddouz, Mohamed, Khalil Azzaoui, Rachid Sabbahi, Moulay Hfid Youssoufi, Meryem Idrissi Yahyaoui, Abdeslam Asehraou, Mohamed El Miz, Belkheir Hammouti, Sergey Shityakov, Mohamed Siaj, and et al. 2024. "Cheminformatics-Based Design and Synthesis of Hydroxyapatite/Collagen Nanocomposites for Biomedical Applications" Polymers 16, no. 1: 85. https://doi.org/10.3390/polym16010085
APA StyleAaddouz, M., Azzaoui, K., Sabbahi, R., Youssoufi, M. H., Yahyaoui, M. I., Asehraou, A., El Miz, M., Hammouti, B., Shityakov, S., Siaj, M., & Mejdoubi, E. (2024). Cheminformatics-Based Design and Synthesis of Hydroxyapatite/Collagen Nanocomposites for Biomedical Applications. Polymers, 16(1), 85. https://doi.org/10.3390/polym16010085

